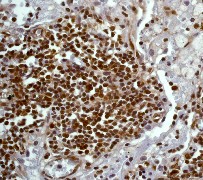

> Antigen, Antibodies, ELISA, Western Blot > Primary Antibody > Monoclonal Antibodies > Stat-5 alpha Antibody (C-term)Brand |
Leading Biology | Catalog Number |
APR10255G |
Product Type |
Monoclonal Antibodies | Field of Research |
|
Product Overview |
We constantly strive to ensure we provide our customers with the best antibodies. As a result of this work we offer this antibody in purified format.
We are in the process of updating our datasheets. If you have any questions regarding this update, please feel free to contact our technical support team.
This product is a high quality Stat-5 alpha antibody (C-term).
|
||
Molecular Weight |
90647 Da
|
||
Cellular Localization |
Antigen Cellular Localization:
Cytoplasm. Nucleus. Note=Translocated into the nucleus in response to phosphorylation
|
||
Host |
Rabbit
|
||
Species Reactivity |
Human, Rat
|
||
Target |
A synthetic peptide corresponding to residues in C-terminus of human Stat5a was used as immunogen. The antibody does not cross-react with other Stat family members.
|
||
Clone |
E289
|
||
Symbol |
STAT5
|
||
GeneID |
|||
UniProt ID |
|||
Function |
Carries out a dual function: signal transduction and activation of transcription. Mediates cellular responses to the cytokine KITLG/SCF and other growth factors. Mediates cellular responses to ERBB4. May mediate cellular responses to activated FGFR1, FGFR2, FGFR3 and FGFR4. Binds to the GAS element and activates PRL-induced transcription. Regulates the expression of milk proteins during lactation.
|
||
Summary |
Signal transducer and activator of transcription 5 (Stat5) functions both in signal transduction and activation of transcription. It has been found that cytoplasmic Stat5 is translocated to the nucleus in response to phosphorylation. Stat5 is tyrosine phosphorylated in response to IL-2, IL-3, IL-7, IL-15, GM-CSF, growth hormone, prolactin, erythropoietin and thrombopoietin (1,2). Tyrosine phosphorylation is required for DNA-binding activity and dimerization. Serine phosphorylation is also required for maximal transcriptional activity. NCoA-1/SRC-1 acts as a coactivator for both the a- and b-isoforms of Stat5 (3).
|
||
Form |
50 mM Tris-Glycine (pH 7.4), 0.15 M NaCl, 40% Glycerol, 0.01% sodium azide and 0.05% BSA. |
||
Storage & Stability |
Store at +4°C short term. For long-term storage, aliquot and store at -20°C or below. Stable for 12 months at -20°C. Avoid repeated freeze-thaw cycles.
|
||
Applications |
WB, IHC
|
||
Dilution |
WB~~1:1000~10000
IHC~~1:100~250
|
||
Synonyms |
Signal transducer and activator of transcription 5A, STAT5A, STAT5
|
||
Images |

A. Western blot analysis on A431 cell lysate using anti- Stat5a RabMAb (Cat. APR10255G), dilution 1:1,000.
B. Immunohistochemical analysis of paraffin-embedded human squamous lung carcinoma using anti-STAT5a RabMAb (Cat. APR10255G). |
||
Specification |
|||
Quantity |
|
||
| Select | Brand | Catalog No. | Product Name | Pack Size | Type | Field of Research | Specification | Quantity | Price(USD) | |
| 1 | Leading Biology | APG02467G | CCK4 / PTK7 Antibody (clone 4F9) | 50 μl | Monoclonal Antibodies |
|
$495.00 | Add Ask | ||
| 2 | Leading Biology | AMM04683G | GALT Antibody (clone 4C11) | 50 μg | Monoclonal Antibodies |
|
$545.00 | Add Ask | ||
| 3 | Leading Biology | AMM01402G | Vimentin (Mesenchymal Cell Marker) Antibody - With BSA and Azide | 50 ug | Monoclonal Antibodies |
|
$395.00 | Add Ask | ||
| 4 | Leading Biology | APR08280G | LTA4H / LTA4 Antibody (clone 9G8) | 50 μl | Monoclonal Antibodies |
|
$495.00 | Add Ask | ||
| 5 | Leading Biology | AMM00172G | CD1a / HTA1 (Mature Langerhans Cells Marker) Antibody - With BSA and Azide | 50 ug | Monoclonal Antibodies |
|
$395.00 | Add Ask | ||
| 6 | Leading Biology | AMM05750G | CEBPA Antibody | 100 μl | Monoclonal Antibodies |
|
$545.00 | Add Ask |
 Leading Biology Inc.
2600 Hilltop DR, Building G, B Suite C138
Richmond, CA, 94806
Tel: 1-661-524(LBI)-0262
Email: info@leadingbiology.com
Leading Biology Inc.
2600 Hilltop DR, Building G, B Suite C138
Richmond, CA, 94806
Tel: 1-661-524(LBI)-0262
Email: info@leadingbiology.com
Complete this form and click send to ask us a question, request a quote or simply say hello.

You have 0 item in your cart

You have 0 item in your inquiry list
